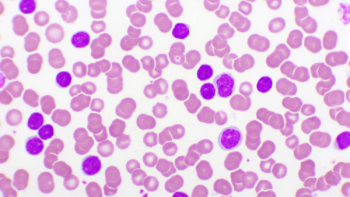

Expansion expected to create additional production capacity, company says.

Expansion expected to create additional production capacity, company says.

Decision based on data collected from patients in the early stages of the disease.

Deal reached with a potential equity value of $3.5 billion.

With the sales boom from COVID-19 products now in the rear-view, a resetting is underway for those in Pharm Exec’s listing of the top biopharma producers—shifting attention to new Rx roads ahead and the steady strategies needed to navigate a bumpy business terrain.

The new era of generative AI is poised to impact pharma marketing and engagement in powerful and lasting ways. But amid all the technological praise, what are the key considerations brand teams must navigate?

Amid the shifting focus from primary care to specialty care, using data-driven tactics can create tailored campaigns and meaningful relationships with nurse practitioners and physician assistants.

Senior editor Fran Pollaro and Morten Nielsen, senior partner for the life sciences practice at Wittkieffer, embark on an insightful exploration of trust in the pharmaceutical industry, discussing its measurement, improvement, and critical role in governance, culture, leadership, and organizational structure, while offering practical advice for industry leaders on embedding transparency, inclusion, and accountability into daily operations.

Transaction expected to provide shareholders with immediate value.

Prevymis to focus on disease in high-risk adult kidney transplant recipients.

Creative audacity and innovation often take a backseat to rigid regulatory adherence in pharma advertising—but there are exceptions.

Ryan Mason, Jeffrey D. Erb to join as chief marketing officer and chief media officer, respectively.

DeepIntent OS expected to give publishers access to company’s comprehensive suite.

Israeli pharmaceutical organization expected to evaluate the offer.

Patients to be selected for treatment based on approved companion diagnostic.

Alliance aims to expand access to innovative healthcare solutions.

Bloomberg Intelligence survey credits increased medication access for potential spike.

Partnership to focus on drug discovery platform.

Inpefa to support multiple cardiovascular issues.

Krystal Biotech treatment to support patients with dystrophic epidermolysis bullosa.

Purchase leaves biotech’s remaining assets on the table.

Advertising pause aims to prevent stimulating further demand, company says.

Treatment supported under agency’s accelerated approval program.

Miebo reported as the first cleared remedy that directly targets tear evaporation.

Biotech company to receive $55 million upfront, per terms of the deal.
Nelarabine injection to be first Shorla product approved in the US.